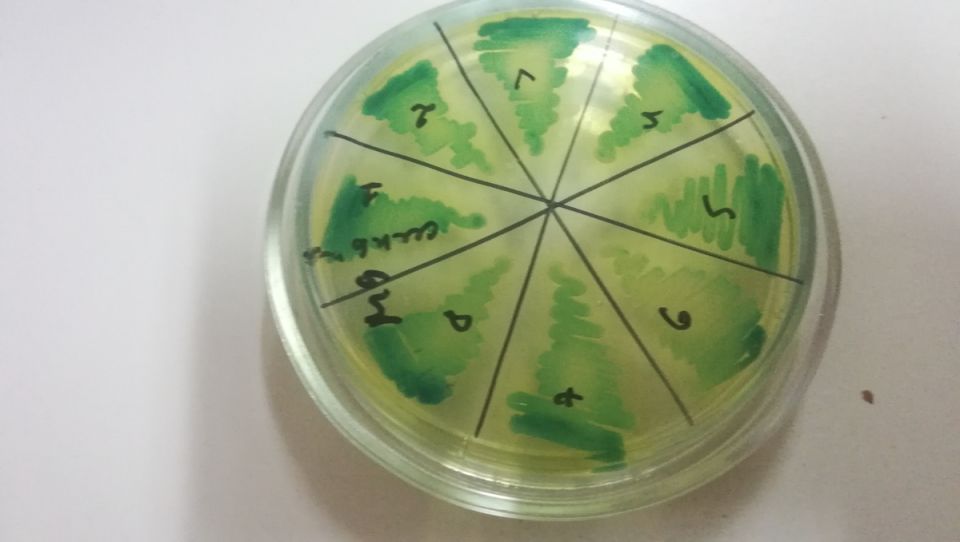
��� ������� ����� ����������� ��� ��� � �������� �����������

Проблема аллергий становится все более актуальной в современном мире, и, к сожалению, число людей, испытывающих на себе её последствия, растёт. Даже сложные медицинские тесты не всегда помогают понять, на что именно реагирует организм...
СМИ
Розы всегда были символом красоты и изысканности, завораживая нас своими великолепными цветами и формами. Хотя порой кажется, что их капризы могут сломить даже опытных садоводов, на самом деле, их можно с успехом выращивать при правильном подходе....
С 2026 года владельцы частных домов, дач и садовых участков столкнутся с изменениями в правилах налогообложения хозяйственных построек, таких как бани, сараи, летние кухни и уличные туалеты. Эти изменения не вводят новый налог, но уточняют...
Итальянская команда Формулы 1 Visa Cash App Racing Bulls недавно представила уникальную ливрею своего болида перед Гран При Лас-Вегаса. Эта особая красочная окраска включает в себя голографические элементы, которые особенно эффектно выглядят в свете...
Подборка простых и доступных рецептов для всей семьи, которые точно оценят даже самые взыскательные гурманы. Это меню станет отличным решением для напряжённой недели, не отнимая много времени и не требуя больших затрат.
Завтраки на любой...
Все любители оригинальных блюд будут в восторге от этого рецепта! Куриные шарики, смешанные с творогом и залитые нежным кабачковым соусом, создают удивительный вкус. Давайте разберем ингредиенты и процесс приготовления.
Необходимые ингредиенты
Для...
Индюшачьи сердечки – незаслуженно забытый деликатес, который можно приготовить множеством способов. Этот питательный субпродукт отлично подходит для жарки, варки или запекания, и его можно добавлять в рагу, супы и даже шашлыки....
Дыня манго представляет собой уникальный сорт, который удивляет своим необычайным вкусом и ароматом. Эта дыня не просто радует гурманов, но и привлекает садоводов благодаря своей высокой урожайности и устойчивости к различным заболеваниям.
История...
Как сообщили в Примводоканале, авария произошла во время планового восстановления водоснабжения после завершения ремонтных работ. При запуске системы произошёл разрыв гидранта в одном из подземных колодцев вследствие давления воды. Устраняет...
С началом весны садоводов ждут не только радости от цветения, но и настоящие испытания — вредители. Важно провести защитные мероприятия, чтобы сохранить растения и обеспечить хороший урожай.
Защита растений до и во время цветения
Совсем скоро май...
Приготовление пиццы может показаться сложным и требующим много времени, но есть и более простые варианты. Этот рецепт, созданный по просьбе дочери, идеально как для повседневного меню, так и для неожиданных гостей, сообщает...
13 декабря, или Андреев день, занимал особое место в народном календаре, особенно для девушек. Этот день был временем, когда гадания о будущем замужестве приобретали особую силу. Святой Андрей был покровителем женского счастья, и все ритуалы...
Новая стратегия: от борьбы к партнерству с природой
Сегодняшние садоводы и агрономы больше не полагаются исключительно на механическую или химическую борьбу с вредителями, болезнями и сорняками. Вместо этого акцент сместился в сторону сотрудничества с...
С 1 января 2025 года в России действует уникальный социальный налоговый вычет, связанный с выполнением нормативов Всероссийского физкультурно-спортивного комплекса «Готов к труду и обороне» (ГТО). Этот шаг стал частью государственной инициативы...
Проблема неприятного запаха из мусорного ведра, казалось бы, не так уж страшна. Достаточно регулярно опорожнять контейнер и избавляться от пищевых отходов, чтобы избежать её. Однако иногда это не помогает, и запах становится невыносимым....
Праздничные дни нередко превращают магазины в настоящие муравейники. Точно так же, как и покупатели в спешке собирательные списки, уничтожают ожидания. Чувство паники, когда не хватает необходимых ингредиентов, может легко нарушить...
Наступила пора дачного сезона, и впереди множество вкусных экспериментов с местными продуктами. В этом году акцент следует сделать на листьях хрена, которые обычно выбрасывают, но из которых можно приготовить отменную аджику. Этот яркий и острый...
Вклад — это более чем просто способ сохранить деньги; он представляет собой шанс увеличить сбережения, минимизируя риски.
Зачем выбирать надежные банки?
При открытии вклада крайне важно выбирать банки, которые находятся в списке системно...
Департамент информационной политики края совместно с Министерством культуры и архивного дела Приморья @minkultpk дали новую жизнь художественному проекту «Портрет героя».Истории о наших защитниках теперь можно не только услышать на сайте «Культурное...
Проект рассказывает об обычных, но таких важных профессиях Новый выпуск смотрите уже сегодня в 19:30. Он посвящён нелёгкой работе военных.Повторы программы будут выходить в течение двух недель до 4-го марта.Также выпуски можно посмотреть в любое время...
Лента новостей
- Из-за ограничений нам сложно поддерживать нормальную работу нашего канала в Telegram. Если у вас установлен МАХ, пожалуйста, подпишитесь на Вести Приморье. Вести Приморье в МАХ// Вести Приморье